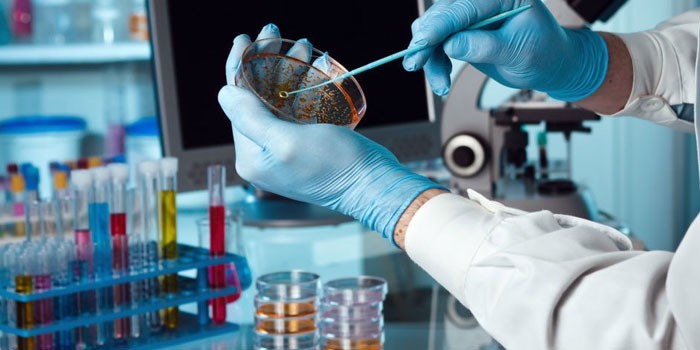
image

Современный метод диагностики помогает выявить причину инфекционно-воспалительных процессов в организме человека. Мазок из зева на микрофлору помогает врачу подобрать адекватное лечение. Анализ поможет исключить тяжелые заболевания – пневмонию, туберкулез, дифтерию.
Что показывает мазок из горла на флору
Исследование проводится с целью определения состава микробиоты носоглотки. Анализ мазка на флору выявляет количество, вид доминирующих микроорганизмов, их чувствительность к медикаментам. На основе полученных данных назначается схема лечения.
Мнение врачей:
Мазок из горла — важный анализ для выявления инфекций верхних дыхательных путей. Врачи рекомендуют сдавать этот анализ при первых признаках заболевания, таких как боль в горле, кашель, насморк. Это поможет точно определить возбудителя инфекции и подобрать эффективное лечение. Для сдачи анализа необходимо обратиться к врачу ЛОРу, который проведет процедуру взятия мазка. Важно помнить, что результаты могут быть ложноположительными или ложноотрицательными, поэтому следует доверять профессионалам и при необходимости повторить анализ для подтверждения диагноза.

Мазок на чувствительность к антибиотикам
Анализ выявляет восприимчивость микроорганизмов к воздействию бактерицидных препаратов. Мазок из горла на чувствительность (антибиотикограмму) редко сдается одновременно с посевом на флору. Препараты-кандидаты зачастую эффективны только in vitro (в пробирке). Решит эту проблему прием антибиотиков широкого спектра действия. Врач назначает анализ на чувствительность к антибиотикам в следующих случаях:
- возникла необходимость в замене лекарственного препарата;
- отмечается привыкание к действию медикамента;
- выбранный бактерицидный препарат неэффективен.
В каких случаях показан бакпосев из зева
Анализ назначается для выявления носительства болезнетворных микробов и определения возбудителя заболеваний ЛОР-органов. Для выявления стафилококковой инфекции в горле берется мазок на стафилококк. Это условно-патогенная бактерия, которая вызывает тонзиллит, пневмонию при определенных условиях – переохлаждении, ослабленном иммунитете.
Анализ на стрептококк назначается для исключения пневмонии, фарингита, скарлатины. С профилактической целью мазок из ротоглотки берется при оформлении медицинской книжки.
Другие показания к бактериологическому исследованию флоры горла:
- подозрение на стрептококковую инфекцию;
- обследование беременных женщин;
- поступление ребенка в дошкольное учреждение;
- госпитализация;
- хирургическое вмешательство;
- дифференциальная диагностика дифтерии, ангины, отита, скарлатины.
Статьи по теме
- Гнойная ангина – признаки и методы терапии в домашних условиях
- Хрипота в горле – как быстро вылечить в домашних условиях
- Боль в горле при глотании у детей и взрослых – возможные заболевания

Опыт других людей
Мазок из горла – это один из наиболее распространенных методов диагностики инфекций верхних дыхательных путей. Люди, сдавшие анализ, отмечают его простоту и относительную безболезненность процедуры. Основное, что говорят пациенты – важность правильной подготовки к сдаче анализа. Необходимо воздержаться от приема пищи и жидкости перед процедурой, чтобы результаты были максимально точными. Пациенты также советуют обратиться к опытному специалисту для проведения мазка, чтобы избежать ошибок и получить достоверные результаты. В целом, сдача мазка из горла – это важный шаг в выявлении инфекций и начало правильного лечения.
Как происходит взятие мазка из зева
Забор биоматериала со слизистой происходит методом соскоба. Пациент запрокидывает голову и широко открывает рот. Врач прижимает его язык медицинским шпателем, затем проводит стерильным ватным тампоном по задней стенке горла. Собранную слизь помещают в пробирку и доставляют в лабораторию.
Методика проведения исследования
Биоматериал высеивается на разные питательные среды и помещается в термостат, где происходит рост микроорганизмов. Производится контрольный осмотр колоний в мазке, во время которого оценивают цвет, плотность, форму культуры, подсчитывают количество микроорганизмов, населяющих слизистую горла. Концентрация бактерий выражается в колониеобразующих единицах (КОЕ).
Помимо посева, для исследования микрофлоры горла используют антигенный гемотест.
Метод выявляет определенные микробные частицы в исследуемом материале. Гемотест используется для выявления бета-гемолитического стрептококка категории А. Метод полимеразной цепной реакции (ПЦР) устанавливает виды микробов по элементам ДНК.

Правила подготовки к анализу
Исследование проводится натощак. За 2–3 суток до сдачи анализа необходимо отказаться от ополаскивателей для рта. Они смывают часть микробной флоры. Желательно не чистить зубы за 2–3 часа до забора биоматериала. Другие правила подготовки к сдаче мазка из горла:
- Исключить прием пищи, напитков за 2–3 часа до забора образцов.
- Не применять мази, спреи с антибиотиками, антисептиками за несколько дней до анализа.
Как расшифровать посев из зева на микрофлору
Результаты анализа вписывают в специальный бланк. В таблице или списке представлены названия микроорганизмов, которые присутствуют на слизистой горла. Рядом указывают концентрацию бактериальных клеток. С
одержание сапрофитных и условно-патогенных микробов в норме не превышает 10³–10⁴ КОЕ/мл, отсутствуют патогенные бактерии.
Сделать правильную расшифровку анализа может только врач-отоларинголог. Болезнетворными считаются:
- гемолитический стрептококк группы А;
- герпес;
- грибки Кандида альбиканс;
- энтеробактерии;
- гемолитический и эпидермальный стафилококки;
- коклюшная палочка Борде-Жангу (возбудитель коклюша).

Что делать, если мазок из носоглотки выявил патологии
Если концентрация патогенных (условно-патогенных) микробов на слизистой горла превышает 10⁵ КОЕ/мл, диагностируется бактериальная инфекция. В этом случае назначаются антибиотики широкого спектра действия. Нередко воспаление купируют бактериофагами. Народные средства применяют как дополнительную помощь. Для предотвращения заражения окружающих рекомендуется:
- применять индивидуальные средства гигиены;
- регулярно проводить дезинфекцию дома (тщательно протирать выключатели, дверные ручки);
- обеззараживать посуду;
- кипятить постельное, нательное белье.
Видео
Внимание!
Информация, представленная в статье, носит ознакомительный характер. Материалы статьи не призывают к самостоятельному лечению. Только квалифицированный врач может поставить диагноз и дать рекомендации по лечению, исходя из индивидуальных особенностей конкретного пациента.
Статья обновлена: 11.02.2019
Частые вопросы
Как правильно сдать мазок из горла?
Для взятия мазка основание языка прижимается медицинским шпателем, а затем врач тампоном проводит по миндалинам, небным дужкам и стенке глотки. Мазок берут исключительно из указанных областей.
Как правильно сдать мазок на инфекции?
воздержаться на 1–2 суток от половых контактов, не применять вагинальные препараты (крема, свечи) и не делать спринцевания в течение 2 суток, перед сдачей мазка на флору рекомендуется не мочиться в течение 2–3 часов.
Как называется мазок из горла на бактерии?
ЛОР-мазок – это диагностическая процедура, в ходе которой производится взятие материала со слизистой оболочки полости носа и зева. Полученные образцы передаются в лабораторию для проведения бактериологического исследования.
Как правильно сдать мазок из зева на микрофлору?
Исследование мазка из зева Мазок из зева берется строго натощак, перед исследованием за 3 часа нельзя принимать пищу, чистить зубы, полоскать рот водой, пить. При проведении исследования на дифтерию берутся два мазка: из зева и носа.
Полезные советы
СОВЕТ №1
Перед сдачей анализа на инфекции из горла необходимо воздержаться от приема пищи и жидкости в течение 2-3 часов, чтобы результат был максимально точным.
СОВЕТ №2
При сдаче мазка из горла важно следовать указаниям медицинского персонала по правильной технике взятия мазка, чтобы избежать ошибок и получить достоверный результат.
СОВЕТ №3
Если у вас есть какие-либо сомнения или вопросы относительно процедуры сдачи анализа на инфекции из горла, не стесняйтесь обратиться к медицинскому персоналу за консультацией.









